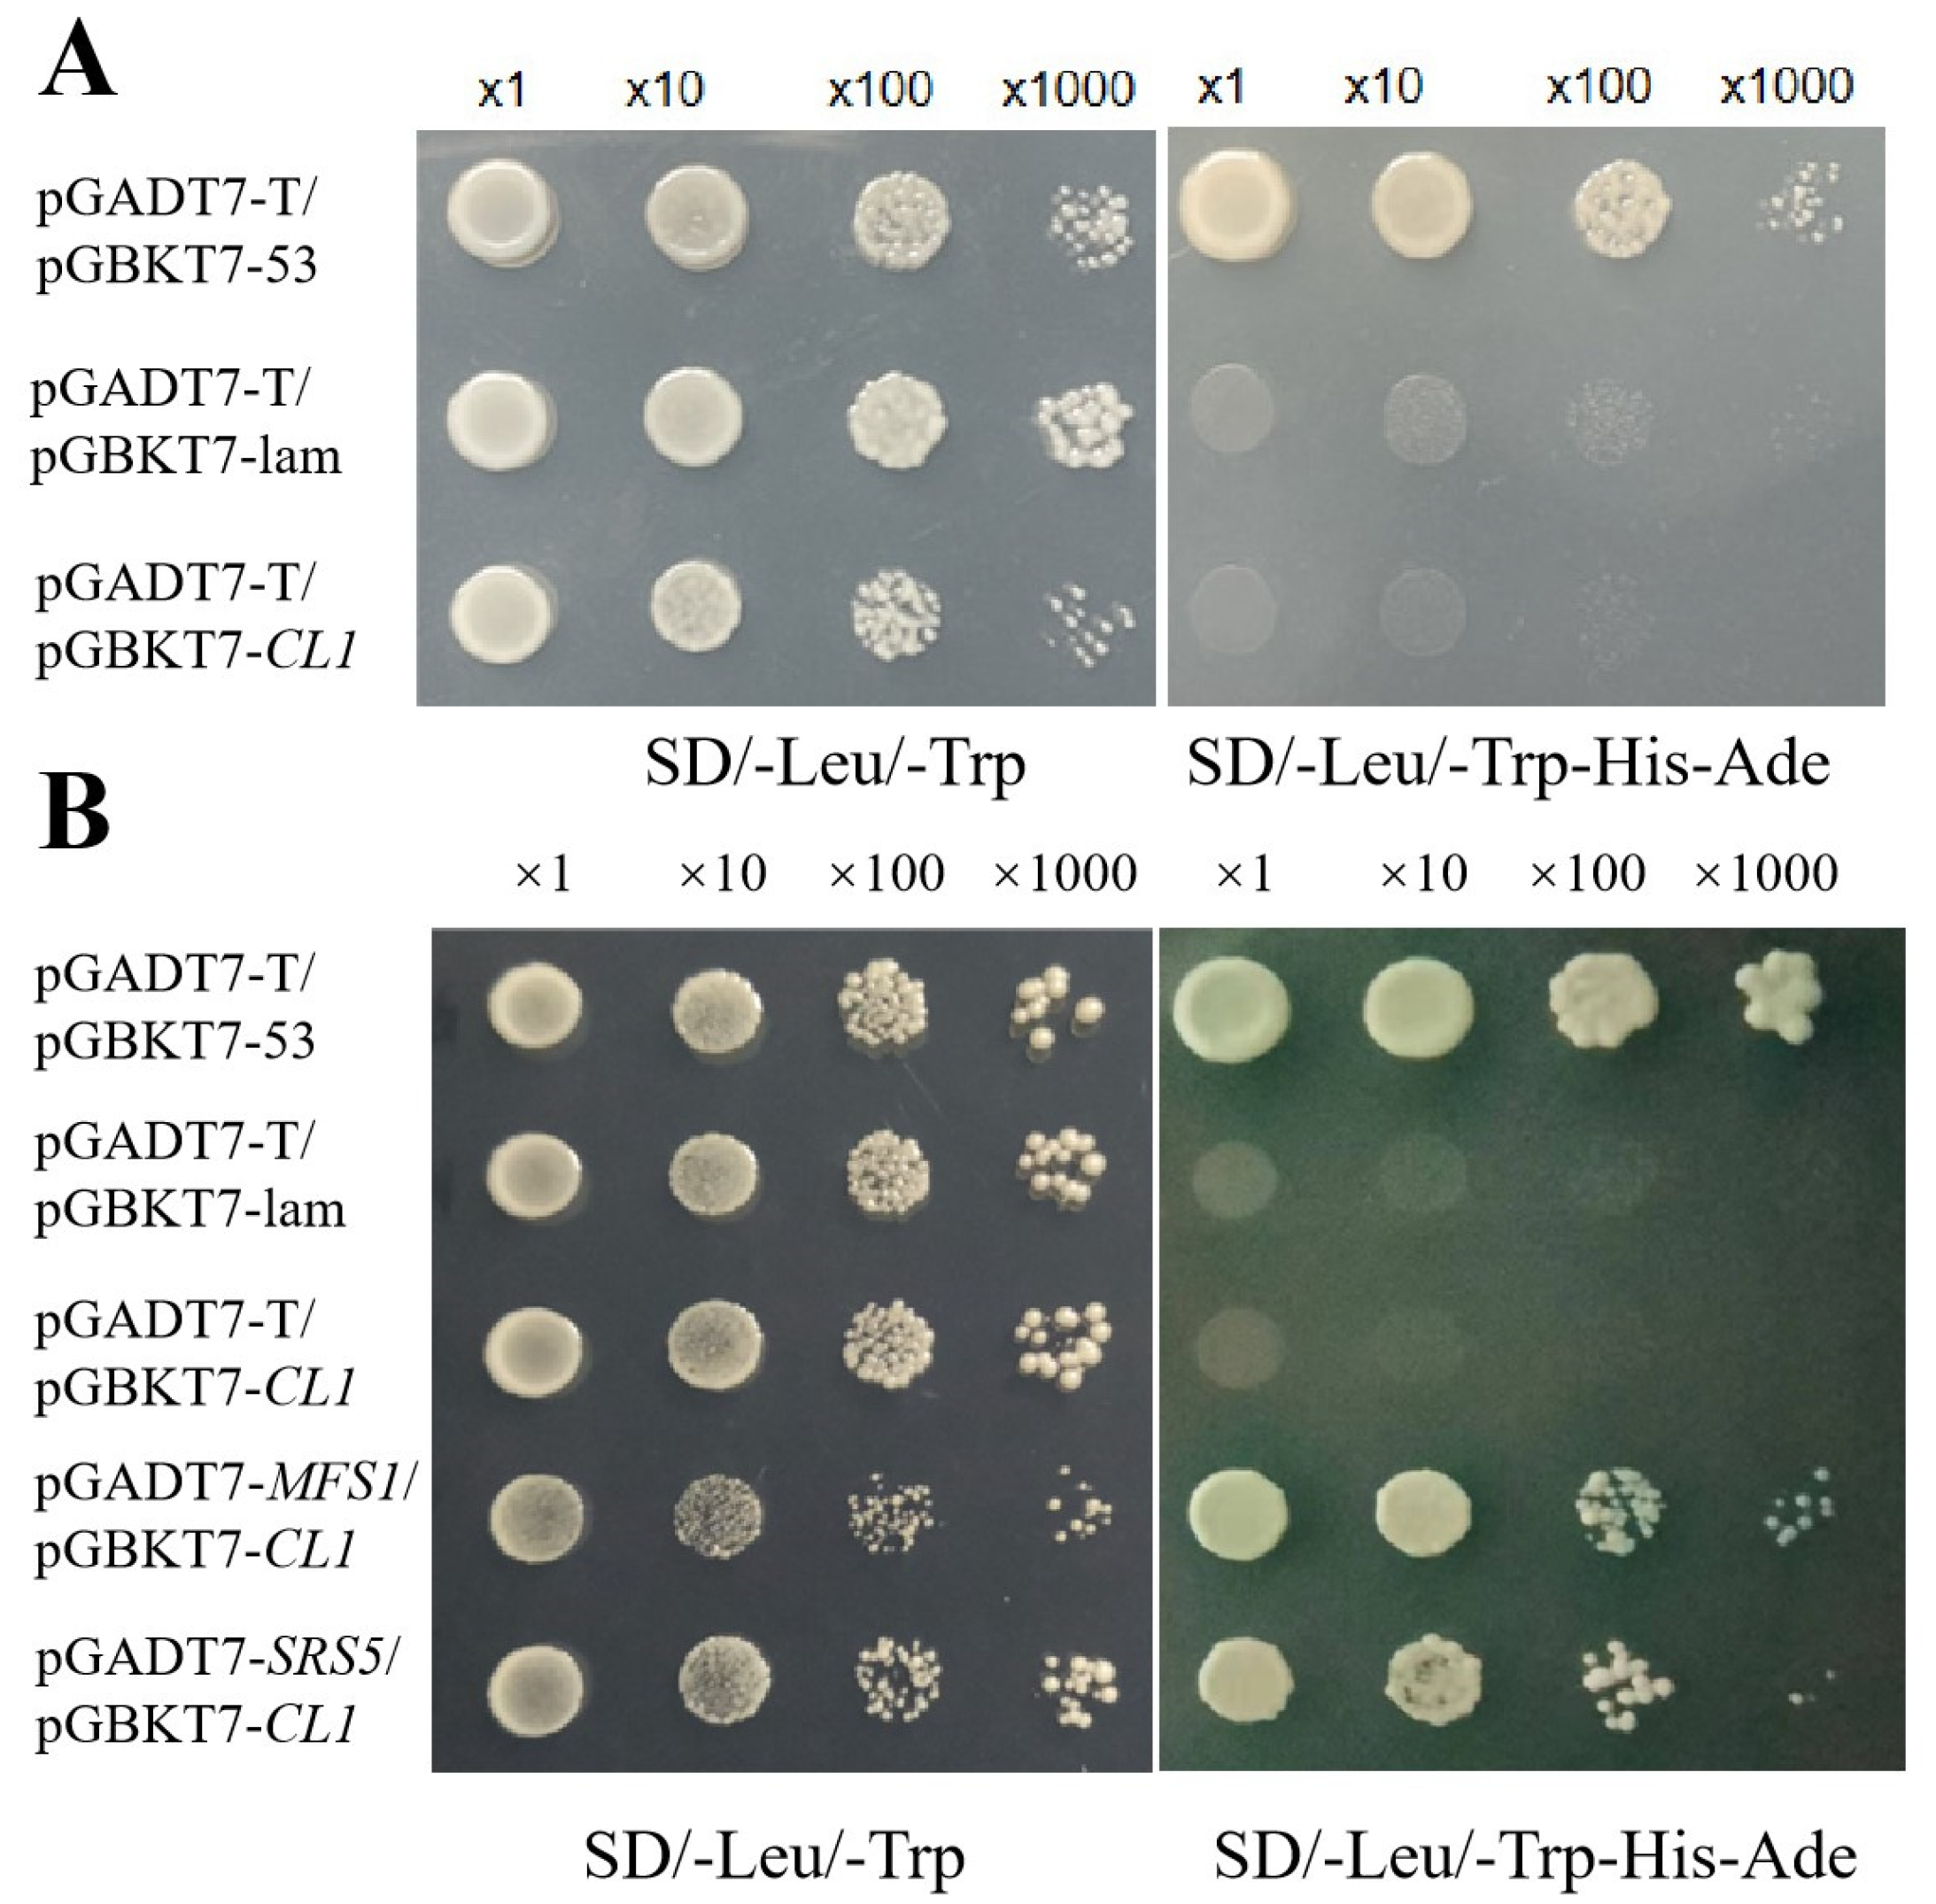
Plants 12 03127 g006

Curling Leaf 1, Encoding a MYB-Domain Protein, Regulates Leaf Morphology and Affects Plant Yield in Rice
Abstract
:1. Introduction
2. Results
2.1. The cl1 Mutant Is Characterized by the Loss of Sclerenchymatous Cells, Resulting in Inward Leaf Curling
2.2. The cl1 Mutant Exhibited a Significant Reduction in 1000-Grain Weight and a Consequent Decrease in Yield
2.3. CL1 Encodes an MYB Transcription Factor
2.4. The Expression Pattern and Subcellular Localization of CL1
2.5. Transcriptome Analysis of the cl1 Mutant
2.6. CL1 Interacts with SRS5 and MFS
3. Discussion
4. Conclusions
5. Materials and Methods
5.1. Plant Materials
5.2. Investigation of Agronomic Traits
5.3. Determination of Photosynthetic Efficiency and Photosynthetic Pigment
5.4. Map-Based Cloning of CL1
5.5. The Expression Pattern and Subcellular Localization of CL1 for RT–PCR Analysis
5.6. Transcriptome Analysis
5.7. Screening of CL1 Interacting Proteins
Supplementary Materials
Author Contributions
Funding
Data Availability Statement
Conflicts of Interest
References
- Yang, S.; Li, W.; Miao, H.; Gan, F.; Qiao, L.; Chang, Y.; Shi, C.H.; Chen, K. REL2, A gene encoding an unknown function protein which contains DUF630 and DUF632 domains controls leaf rolling in rice. Rice 2016, 9, 37. [Google Scholar] [CrossRef]
- Liu, X.; Li, M.; Liu, K.; Tang, D.; Sun, M.; Li, Y.; Shen, Y.; Du, G.; Cheng, Z. Semi-Rolled Leaf2 modulates rice leaf rolling by regulating abaxial side cell differentiation. J. Exp. Bot. 2016, 67, 2139–2150. [Google Scholar] [CrossRef] [PubMed]
- Ma, L.; Sang, X.; Zhang, T.; Yu, Z.; Li, Y.; Zhao, F.; Wang, Z.; Wang, Y.; Yu, P.; Wang, N.; et al. ABNORMAL VASCULAR BUNDLES regulates cell proliferation and procambium cell establishment during aerial organ development in rice. New Phytol. 2017, 231, 275–286. [Google Scholar] [CrossRef] [PubMed]
- Xu, P.; Ali, A.; Han, B.; Wu, X. Current advances in molecular basis and mechanisms regulating leaf morphology in rice. Front. Plant Sci. 2018, 23, 1528. [Google Scholar] [CrossRef] [PubMed]
- Micol, J.L.; Hake, S. The development of plant leaves. Plant Physiol. 2003, 131, 389–394. [Google Scholar] [CrossRef] [PubMed]
- Fan, Y.B.; Liang, W.Q. Research progress on the mechanism of leaf polaroty establishment in rice. J. Shanghai Jiaotong Univ. (Agric. Sci.) 2014, 32, 16–22. [Google Scholar]
- Xu, J.; Wang, L.; Qian, Q. Research advance in molecule regulation mechanism of leaf morphogenesis in rice (Oryza sativa L.). Acta Agron. Sin. 2013, 39, 767–774. [Google Scholar] [CrossRef]
- Hibara, K.; Obara, M.; Hayashida, E.; Abe, M.; Ishimaru, T.; Satoh, H.; Itoh, J.; Nagato, Y. The ADAXIALIZED LEAF1 gene functions in leaf and embryonic pattern formation in rice. Dev. Biol. 2009, 334, 345–354. [Google Scholar] [CrossRef] [PubMed]
- Li, Y.; Yang, Y.; Liu, Y.; Li, D.; Zhao, Y.; Li, Z.; Liu, Y.; Jiang, D.; Li, J.; Zhou, H.; et al. Overexpression of OsAGO1b induces adaxially rolled leaves by affecting leaf abaxial sclerenchymatous cell development in rice. Rice 2019, 12, 60. [Google Scholar] [CrossRef] [PubMed]
- Chen, Z.; Teng, S.; Liu, D.; Chang, Y.; Zhang, L.; Cui, X.; Wu, J.; Ai, P.; Sun, X.; Lu, T.; et al. RLM1, Encoding an R2R3 MYB transcription factor, regulates the development of secondary cell wall in rice. Front. Plant Sci. 2022, 13, 905111. [Google Scholar] [CrossRef]
- Chen, W.; Sheng, Z.; Cai, Y.; Li, Q.; Wei, X.; Xie, L.; Jiao, G.; Shao, G.; Tang, S.; Wang, J.; et al. Rice morphogenesis and chlorophyll accumulation is regulated by the protein encoded by NRL3 and its interaction with NAL9. Front. Plant Sci. 2019, 10, 175. [Google Scholar] [CrossRef]
- Chen, Q.; Xie, Q.; Gao, J.; Wang, W.; Sun, B.; Liu, B.; Zhu, H.; Peng, H.; Zhao, H.; Liu, C.; et al. Characterization of rolled and Erect Leaf 1 in regulating leave morphology in rice. J. Exp. Bot. 2015, 66, 6047–6058. [Google Scholar] [CrossRef] [PubMed]
- Liang, J.; Guo, S.; Sun, B.; Liu, Q.; Chen, X.; Peng, H.; Zhang, Z.; Xie, Q. Constitutive expression of REL1 confers the rice response to drought stress and abscisic acid. Rice 2018, 11, 59. [Google Scholar] [CrossRef]
- Fang, J.; Guo, T.; Xie, Z.; Chun, Y.; Zhao, J.; Peng, L.; Zafar, S.A.; Yuan, S.; Xiao, L.; Li, X. The URL1-ROC5-TPL2 transcriptional repressor complex represses the ACL1 gene to modulate leaf rolling in rice. Plant Physiol. 2021, 185, 1722–1744. [Google Scholar] [CrossRef] [PubMed]
- Li, L.; Shi, Z.; Li, L.; Shen, G.; Wang, X.; An, L.; Zhang, J. Overexpression of ACL1 (abaxially curled leaf 1) increased bulliform cells and induced abaxial curling of leaf blades in rice. Mol. Plant 2010, 3, 807–817. [Google Scholar] [CrossRef] [PubMed]
- Zhang, G.; Hou, X.; Wang, L.; Xu, J.; Chen, J.; Fu, X.; Shen, N.; Nian, J.; Jiang, Z.; Hu, J.; et al. PHOTO-SENSITIVE LEAF ROLLING 1 encodes a polygalacturonase that modifies cell wall structure and drought tolerance in rice. New Phytol. 2021, 229, 890–901. [Google Scholar] [CrossRef] [PubMed]
- Jiao, Y.; Wang, Y.; Xue, D.; Wang, J.; Yan, M.; Liu, G.; Dong, G.; Zeng, D.; Lu, Z.; Zhu, X.; et al. Regulation of OsSPL14 by OsmiR156 defines ideal plant architecture in rice. Nat. Genet. 2010, 42, 541–544. [Google Scholar] [CrossRef] [PubMed]
- Miura, K.; Ikeda, M.; Matsubara, A.; Song, X.J.; Ito, M.; Asano, K.; Matsuoka, M.; Kitano, H.; Ashikari, M. OsSPL14 promotes panicle branching and higher grain productivity in rice. Nat. Genet. 2010, 42, 545–549. [Google Scholar] [CrossRef]
- You, J.; Xiao, W.; Zhou, Y.; Shen, W.; Ye, L.; Yu, P.; Yu, G.; Duan, Q.; Zhang, X.; He, Z.; et al. The APC/CTAD1-WIDE LEAF 1-NARROW LEAF 1 pathway controls leaf width in rice. Plant Cell 2022, 34, 4313–4328. [Google Scholar] [CrossRef]
- Zhai, L.; Yan, A.; Shao, K.; Wang, S.; Wang, Y.; Chen, Z.H.; Xu, J. Large Vascular Bundle Phloem Area 4 enhances grain yield and quality in rice via source-sink-flow. Plant Physiol. 2023, 191, 317–334. [Google Scholar] [CrossRef]
- Lin, L.; Zhao, Y.; Liu, F.; Chen, Q.; Qi, J. Narrow leaf 1 (NAL1) regulates leaf shape by affecting cell expansion in rice (Oryza sativa L.). Biochem. Biophys. Res. Commun. 2019, 516, 957–962. [Google Scholar] [CrossRef]
- Hu, J.; Wang, Y.; Fang, Y.; Zeng, L.; Xu, J.; Yu, H.; Shi, Z.; Pan, J.; Zhang, D.; Kang, S.; et al. A rare allele of GS2 enhances grain size and grain yield in rice. Mol. Plant 2015, 8, 1455–1465. [Google Scholar] [CrossRef] [PubMed]
- Wang, Y.; Xiong, G.; Hu, J.; Jiang, L.; Yu, H.; Xu, J.; Fang, Y.; Zeng, L.; Xu, E.; Xu, J.; et al. Copy number variation at the GL7 locus contributes to grain size diversity in rice. Nat. Genet. 2015, 47, 944–948. [Google Scholar] [CrossRef] [PubMed]
- Wang, X.; Wang, M.; Ji, Z. Functional characterization of the glycoside hydrolase encoding gene OsBE1 during chloroplast development in Oryza sativa. Acta Agron. Sin. 2014, 40, 2090–2097. [Google Scholar] [CrossRef]
- Ramamoorthy, R.; Vishal, B.; Ramachandran, S.; Kumar, P. The OsPS1-F gene regulates growth and development in rice by modulating photosynthetic electron transport rate. Plant Cell Rep. 2018, 37, 377–385. [Google Scholar] [CrossRef] [PubMed]
- Zhang, Q.; Zhang, J.; Yang, D.; Li, Y.; Li, S.; Zhu, Y. Characterisation and immunolocalisation of a pollen-specific calmodulin-binding protein from rice. Funct. Plant Biol. 2006, 33, 555–562. [Google Scholar] [CrossRef]
- Li, S.; Zhou, J.; Xiang, S.; Wei, S. UVI_02019870, a Puptive Effector from Ustilaginoidea virens, interacts with a chloroplastic-like protein OsCPL1. Phyton-Int. J. Exp. Bot. 2020, 89, 681–690. [Google Scholar] [CrossRef]
- Zhou, L.; Chen, S.; Cai, M.; Cui, S.; Ren, Y.; Zhang, X.; Liu, T.; Zhou, C.; Jin, X.; Zhang, L.; et al. ESCRT-III component OsSNF7.2 modulates leaf rolling by trafficking and endosomal degradation of auxin biosynthetic enzyme OsYUC8 in rice. J. Integr. Plant Biol. 2023, 65, 1408–1422. [Google Scholar] [CrossRef] [PubMed]
- Hwang, S.; Koper, K.; Satoh, H.; Okita, T. Rice endosperm starch phosphorylase (Pho1) assembles with Disproportionating Enzyme (Dpe1) to form a protein complex that enhances synthesis of malto-oligosaccharides. J. Biol. Chem. 2016, 291, 19994–20007. [Google Scholar] [CrossRef] [PubMed]
- Shen, B.; Wang, L.; Lin, X.; Yao, Z.; Xu, H.; Zhu, C.; Teng, H.; Cui, L.; Liu, E.; Zhang, J.; et al. Engineering a new chloroplastic photorespiratory bypass to increase photosynthetic efficiency and productivity in rice. Mol. Plant 2019, 12, 199–214. [Google Scholar] [CrossRef]
- Wang, Z.; Zhou, Y.; Ren, X.; Wei, K.; Fan, X.; Huang, L.; Zhao, D.; Zhang, L.; Zhang, C.; Liu, Q.; et al. Co-Overexpression of two key source genes, OsBMY4 and OsISA3, improves multiple key traits of rice seeds. J. Agric. Food Chem. 2023, 71, 615–625. [Google Scholar] [CrossRef] [PubMed]
- Du, L.; Xu, F.; Fang, J.; Gao, S.; Tang, J.; Fang, S.; Wang, H.; Tong, H.; Zhang, F.; Chu, J.; et al. Endosperm sugar accumulation caused by mutation of PHS8/ISA1 leads to pre-harvest sprouting in rice. Plant J. 2018, 95, 545–556. [Google Scholar] [CrossRef]
- Mou, S.; Shi, L.; Lin, W.; Liu, Y.; Shen, L.; Guan, D.; He, S. Over-Expression of rice CBS domain containing protein, OsCBSX3, confers rice resistance to magnaporthe oryzae inoculation. Int. J. Mol. Sci. 2015, 16, 15903–15917. [Google Scholar] [CrossRef] [PubMed]
- Kammerer, B.; Fischer, K.; Hilpert, B.; Schubert, S.; Gutensohn, M.; Weber, A.; Flügge, U. Molecular characterization of a carbon transporter in plastids from heterotrophic tissues: The glucose 6-phosphate/phosphate antiporter. Plant Cell 1998, 10, 105–117. [Google Scholar] [CrossRef] [PubMed]
- Li, W.; Wang, K.; Chern, M.; Liu, Y.; Zhu, Z.; Liu, J.; Zhu, X.; Yin, J.; Ran, L.; Xiong, J.; et al. Sclerenchyma cell thickening through enhanced lignification induced by OsMYB30 prevents fungal penetration of rice leaves. New Phytol. 2020, 226, 1850–1863. [Google Scholar] [CrossRef] [PubMed]
- Nishimura, H.; Himi, E.; Eun, C.; Takahashi, H.; Qian, Q.; Tsugane, K.; Maekawa, M. Transgenerational activation of an autonomous DNA transposon, Dart1-24, by 5-azaC treatment in rice. Theor. Appl. Genet. 2019, 132, 3347–3355. [Google Scholar] [CrossRef]
- Yang, C.; Hu, H.; Ren, H.; Kong, Y.; Lin, H.; Guo, J.; Wang, L.; He, Y.; Ding, X.; Grabsztunowicz, M.; et al. LIGHT-INDUCED RICE1 regulates light-dependent attachment of LEAF-TYPE FERREDOXIN-NADP+ OXIDOREDUCTASE to the thylakoid membrane in rice and Arabidopsis. Plant Cell 2016, 28, 712–728. [Google Scholar] [CrossRef] [PubMed]
- Li, Z.; Mo, W.; Jia, L.; Xu, Y.; Tang, W.; Yang, W.; Guo, Y.; Lin, R. Rice FLUORESCENT1 is involved in the regulation of chlorophyll. Plant Cell Physiol. 2019, 60, 2307–2318. [Google Scholar] [CrossRef]
- Lv, X.; Shi, Y.; Xu, X.; Wei, Y.; Wang, H.; Zhang, X.; Wu, J. Oryza sativa Chloroplast Signal Recognition Particle 43 (OscpSRP43) is required for chloroplast development and photosynthesis. PLoS ONE 2015, 10, e0143249. [Google Scholar] [CrossRef]
- Meng, Q.; Zhang, W.; Hu, X.; Shi, X.; Chen, L.; Dai, X.; Qu, H.; Xia, Y.; Liu, W.; Gu, M.; et al. Two ADP-glucose pyrophosphorylase subunits, OsAGPL1 and OsAGPS1, modulate phosphorus homeostasis in rice. Plant J. 2020, 104, 1269–1284. [Google Scholar] [CrossRef]
- Dey, A.; Samanta, M.; Gayen, S.; Maiti, M. The sucrose non-fermenting 1-related kinase 2 gene SAPK9 improves drought tolerance and grain yield in rice by modulating cellular osmotic potential, stomatal closure and stress-responsive gene expression. BMC Plant Biol. 2016, 16, 158. [Google Scholar] [CrossRef] [PubMed]
- Fujita, N.; Yoshida, M.; Asakura, N.; Ohdan, T.; Miyao, A.; Hirochika, H.; Nakamura, Y. Function and characterization of starch synthase I using mutants in rice. Plant Physiol. 2006, 140, 1070–1084. [Google Scholar] [CrossRef] [PubMed]
- Zhang, J.; Nallamilli, B.; Mujahid, H.; Peng, Z. OsMADS6 plays an essential role in endosperm nutrient accumulation and is subject to epigenetic regulation in rice (Oryza sativa). Plant J. 2010, 64, 604–617. [Google Scholar] [CrossRef]
- Zeng, Z.; Xiong, F.; Yu, X.; Gong, X.; Luo, J.; Jiang, Y.; Kuang, H.; Gao, B.; Niu, X.; Liu, Y. Overexpression of a glyoxalase gene, OsGly I, improves abiotic stress tolerance and grain yield in rice (Oryza sativa L.). Plant Physiol. Biochem. 2016, 109, 62–71. [Google Scholar] [CrossRef]
- Ueda, K.; Yoshimura, F.; Miyao, A.; Hirochika, H.; Nonomura, K.; Wabiko, H. Collapsed abnormal pollen1 gene encoding the Arabinokinase-like protein is involved in pollen development in rice. Plant Physiol. 2013, 162, 858–871. [Google Scholar] [CrossRef] [PubMed]
- Fujita, N.; Yoshida, M.; Kondo, T.; Saito, K.; Utsumi, Y.; Tokunaga, T.; Nishi, A.; Satoh, H.; Park, J.; Jane, J.; et al. Characterization of SSIIIa-deficient mutants of rice: The function of SSIIIa and pleiotropic effects by SSIIIa deficiency in the rice endosperm. Plant Physiol. 2007, 144, 2009–2023. [Google Scholar] [CrossRef]
- Zhang, Z.; Tan, J.; Chen, Y.; Sun, Z.; Yan, X.; Ouyang, J.; Li, S.; Wang, X. New fructokinase, OsFRK3,regulates starch accumulation and grain filling in rice. J. Agric. Food Chem. 2023, 71, 1056–1066. [Google Scholar] [CrossRef] [PubMed]
- Hirose, T.; Scofield, G.N.; Terao, T. An expression analysis profile for the entire sucrose synthase gene family in rice. Plant Sci. 2008, 174, 534–543. [Google Scholar] [CrossRef]
- Chen, X.; Ji, Y.; Zhao, W.; Niu, H.; Yang, X.; Jiang, X.; Zhang, Y.; Lei, J.; Yang, H.; Chen, R.; et al. Fructose-6-phosphate-2-kinase/fructose-2,6-bisphosphatase regulates energy metabolism and synthesis of storage products in developing rice endosperm. Plant Sci. 2023, 326, 111503. [Google Scholar] [CrossRef]
- Segami, S.; Kono, I.; Ando, T.; Yano, M.; Kitano, H.; Miura, K.; Iwasaki, Y. Small and round seed 5 gene encodes alpha-tubulin regulating seed cell elongation in rice. Rice 2012, 5, 4. [Google Scholar] [CrossRef]
- Segami, S.; Takehara, K.; Yamamoto, T.; Kido, S.; Kondo, S.; Iwasaki, Y.; Miura, K. Overexpression of SRS5 improves grain size of brassinosteroid-related dwarf mutants in rice (Oryza sativa L.). Breed. Sci. 2017, 67, 393–397. [Google Scholar] [CrossRef] [PubMed]
- Lu, J.; Wang, C.; Wang, H.; Zheng, H.; Bai, W.; Lei, D.; Tian, Y.; Xiao, Y.; You, S.; Wang, Q.; et al. OsMFS1/OsHOP2 complex participates in rice male and female development. Front. Plant Sci. 2020, 11, 518. [Google Scholar] [CrossRef]
- Yu, N.; Liang, Y.; Wang, Q.; Peng, X.; He, Z.; Hou, X. Transcriptomic analysis of OsRUS1 overexpression rice lines with rapid and dynamic leaf rolling morphology. Sci. Rep. 2022, 12, 6736. [Google Scholar] [CrossRef]
- Preciado, J.; Begcy, K.; Liu, T. The Arabidopsis HDZIP class II transcription factor ABA INSENSITIVE TO GROWTH 1 functions in leaf development. J. Exp. Bot. 2022, 73, 1978–1991. [Google Scholar] [CrossRef]
- Huang, Z.; Du, Z.; Wang, J. Research progress on rolled leaf traits and molecular regulation mechanism in rice(Oryza staiva). Mol. Plant Breed. 2021, 19, 7604–7611. [Google Scholar] [CrossRef]
- Hu, Y.X.; Feng, S.Y. Plant tissue under light microscope—Sclerenchyma (part 2). Plants 1984, 5, 2. [Google Scholar]
- Candela, H.; Johnston, R.; Gerhold, A.; Foster, T.; Hake, S. The milkweed pod1 gene encodes a KANADI protein that is required for abaxial/adaxial patterning in maize leaves. Plant Cell. 2008, 20, 2073–2087. [Google Scholar] [CrossRef]
- Reinhart, B.; Liu, T.; Newell, N.; Magnani, E.; Huang, T.; Kerstetter, R.; Michaels, S.; Barton, M. Establishing a framework for the Ad/abaxial regulatory network of Arabidopsis: Ascertaining targets of class III homeodomain leucine zipper and KANADI regulation. Plant Cell 2013, 25, 3228–3249. [Google Scholar] [CrossRef] [PubMed]
- Zhang, G.; Xu, Q.; Zhu, X.; Qian, Q.; Xue, H. SHALLOT-LIKE1 is a KANADI transcription factor that modulates rice leaf rolling by regulating leaf abaxial cell development. Plant Cell 2009, 21, 719–735. [Google Scholar] [CrossRef]
- Ren, D.; Cui, Y.; Hu, H.; Xu, Q.; Rao, Y.; Yu, X.; Zhang, Y.; Wang, Y.; Peng, Y.; Zeng, D.; et al. AH2 encodes a MYB domain protein that determines hull fate and affects grain yield and quality in rice. Plant J. 2019, 100, 813–824. [Google Scholar] [CrossRef]
- Luan, W.; Liu, Y.; Zhang, F.; Song, Y.; Wang, Z.; Peng, Y.; Sun, Z. OsCD1 encodes a putative member of the cellulose synthase-like D sub-family and is essential for rice plant architecture and growth. Plant Biotechnol. J. 2011, 9, 513–524. [Google Scholar] [CrossRef]
- Zhao, M.; Wei, X.; Ma, L. Identification, gene mapping and candidate gene prediction of a late-stage rolled leaf mutant lrl1 in rice (Oryza staiva L.). Chin. Sci. Bull. 2015, 60, 3133–3143. [Google Scholar]
- Zhang, J. A Genetic Study of a Rolling Leaf Mutant SHALLOT-LIKE 2 Reveals Complex Nature in Regulation of Bulliform Cell; Nanjing Agricultural University: Nanjing, China, 2015. [Google Scholar]
- Ouyang, X.; Zhong, X.; Chang, S.; Qian, Q.; Zhang, Y.; Zhu, X. Partially functional NARROW LEAF1 balances leaf photosynthesis and plant architecture for greater rice yield. Plant Physiol. 2022, 189, 772–789. [Google Scholar] [CrossRef]
- Hirotsu, N.; Ujiie, K.; Perera, I.; Iri, A.; Kashiwagi, T.; Ishimaru, K. Partial loss-of-function of NAL1 alters canopy photosynthesis by changing the contribution of upper and lower canopy leaves in rice. Sci. Rep. 2017, 7, 15958. [Google Scholar] [CrossRef] [PubMed]
- Fujita, D.; Trijatmiko, K.; Tagle, A.; Sapasap, M.; Koide, Y.; Sasaki, K.; Tsakirpaloglou, N.; Gannaban, R.; Nishimura, T.; Yanagihara, S.; et al. NAL1 allele from a rice landrace greatly increases yield in modern indica cultivars. Proc. Natl. Acad. Sci. USA 2013, 110, 20431–20436. [Google Scholar] [CrossRef]
- Zhang, G.; Li, S.; Wang, L.; Ye, W.; Zeng, D.; Rao, Y.; Peng, Y.; Hu, J.; Yang, Y.; Xu, J.; et al. LSCHL4 from Japonica Cultivar, which is allelic to NAL1, increases yield of indica super rice 93-11. Mol. Plant 2014, 7, 1350–1364. [Google Scholar] [CrossRef] [PubMed]
- Feng, P.; Xing, Y.; Liu, S.; Guo, S.; Zhu, M.; Lou, Q.; Sang, X.; He, G.; Wang, N. Characterization and Gene Mapping of Rolled Leaf Mutant 28 (rl28) in Rice (Oryza sativa L.). Acta Agron. Sin. 2015, 41, 1164–1171. [Google Scholar] [CrossRef]
- Murat, N.; Yang, Y. Comparative study on determination methods of chlorophyll content in wheat. Jiangsu Agric. Sci. 2021, 49, 156–159. [Google Scholar] [CrossRef]
- Chen, X.; Liu, Y.; Ma, B. Design and Practice of a New Teaching Project of the Map-based Cloning Experiment in Genetics. Chin. Bull. Bot. 2019, 54, 797–803. [Google Scholar]
- Shumskaya, M.; Quinlan, R.; Wurtzel, E. Elucidating carotenoid biosynthetic enzyme localization and interactions using fluorescent microscopy. Methods Mol. Biol. 2020, 2083, 223–234. [Google Scholar] [CrossRef] [PubMed]
- Fang, Z.; Tang, R.; Long, L. Screening of OsHDA703 interaction protein and the mechanisms of resistanting to rice stripe virus. J. Beijing Univ. Agric. 2022, 37, 1–6. [Google Scholar] [CrossRef]

Disclaimer/Publisher’s Note: The statements, opinions and data contained in all publications are solely those of the individual author(s) and contributor(s) and not of MDPI and/or the editor(s). MDPI and/or the editor(s) disclaim responsibility for any injury to people or property resulting from any ideas, methods, instructions or products referred to in the content. |
© 2023 by the authors. Licensee MDPI, Basel, Switzerland. This article is an open access article distributed under the terms and conditions of the Creative Commons Attribution (CC BY) license (https://creativecommons.org/licenses/by/4.0/).
Share and Cite
Guo, D.; Chen, L.; Liu, S.; Jiang, W.; Ye, Q.; Wu, Z.; Wang, X.; Hu, X.; Zhang, Z.; He, H.; et al. Curling Leaf 1, Encoding a MYB-Domain Protein, Regulates Leaf Morphology and Affects Plant Yield in Rice. Plants 2023, 12, 3127. https://doi.org/10.3390/plants12173127
Guo D, Chen L, Liu S, Jiang W, Ye Q, Wu Z, Wang X, Hu X, Zhang Z, He H, et al. Curling Leaf 1, Encoding a MYB-Domain Protein, Regulates Leaf Morphology and Affects Plant Yield in Rice. Plants. 2023; 12(17):3127. https://doi.org/10.3390/plants12173127
Chicago/Turabian StyleGuo, Dandan, Lianghai Chen, Shiqiang Liu, Wenxiang Jiang, Qing Ye, Zheng Wu, Xiaoqing Wang, Xiafei Hu, Zelin Zhang, Haohua He, and et al. 2023. "Curling Leaf 1, Encoding a MYB-Domain Protein, Regulates Leaf Morphology and Affects Plant Yield in Rice" Plants 12, no. 17: 3127. https://doi.org/10.3390/plants12173127
APA StyleGuo, D., Chen, L., Liu, S., Jiang, W., Ye, Q., Wu, Z., Wang, X., Hu, X., Zhang, Z., He, H., & Hu, L. (2023). Curling Leaf 1, Encoding a MYB-Domain Protein, Regulates Leaf Morphology and Affects Plant Yield in Rice. Plants, 12(17), 3127. https://doi.org/10.3390/plants12173127

